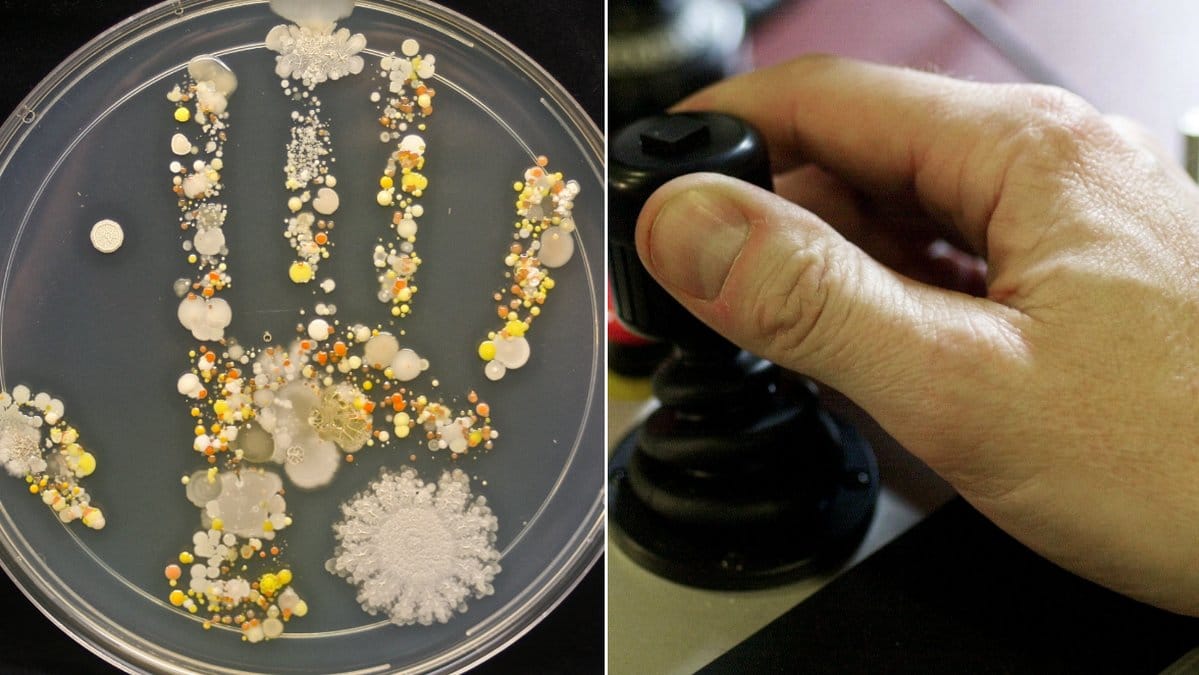

Vilket ska bevisas. Så Tasha Sturm visade upp det genom att göra ett väldigt speciellt handavtryck som visar hur mycket bakterier som hennes åttaårige son har på handen. Åtminstone efter att bakterierna i handavtrycket odlats i något dygn.
Och det är tydligt – det är fett många.
Foto: Tasha Sturm/microbeworld.com
Men frågan är dock – är det farligt? Well, det är lite svårt att säga eftersom att vi inte vet vilka bakterier som faktiskt finns på handavtrycket skriver Vox. Däremot har just Vox satt ihop en guide för hur du gör ditt eget avtryck.
Se här.